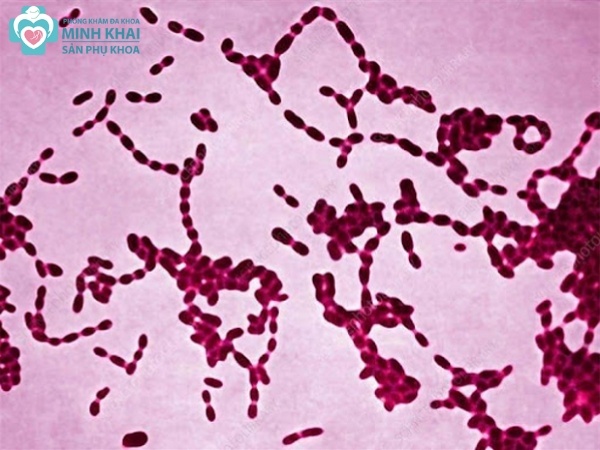

Tìm hiểu bệnh hạ cam mềm ở nam giới
Bệnh hạ cam mềm là căn bệnh tình dục nguy hiểm và phổ biến ở nam giới. Hãy cùng tìm hiểu thêm thông tin về chúng trong bài viết dưới đây nhé.
Bệnh hạ cam mềm là gì?
Hạ cam mềm là căn bệnh phụ khoa mà nam giới hay mắc phải khi quan hệ tình dục thiếu các biện pháp an toàn. Chúng được gây ra bởi một loại trực khuẩn gram âm có tên gọi Haemophilus ducreyi. Loại vi khuẩn này sẽ xâm nhập và tấn công trực tiếp vào cơ thể thông qua niêm mạc, lớp mô da ở xung quanh bộ phận sinh dục. Khi nhiễm bệnh, các triệu chứng lở loét, viêm nhiễm đường sinh dục kéo theo hàng loạt biến chứng nguy hiểm sẽ xuất hiện.
Bệnh hạ cam mềm có tốc độ lây lan nhanh chóng và làm tăng nguy cơ lây nhiễm các chứng bệnh tình dục khác như giang mai, lậu,... Bởi phần dịch tiết và máu từ vết mủ loét tiết ra dễ truyền mầm bệnh khi quan hệ bằng miệng, âm đạo, hậu môn hay thậm chí cả khi tiếp xúc da thông thường. Bệnh có thời gian ủ bệnh khá ngắn và thường tiến lên cấp tính ngay sau đó nếu không phát hiện và chữa trị kịp thời, đúng cách.
Dấu hiệu thường thấy khi mắc bệnh hạ cam mềm
Hạ cam mềm thường có thời gian ủ bệnh trong khoảng 3-7 ngày trước khi các triệu chứng xuất hiện. Thậm chí có những người sau vài tuần sau khi quan hệ với người nhiễm bệnh mới bắt đầu có những biểu hiện đầu tiên. Một số những dấu hiệu nổi bật trên cơ thể khi mắc bệnh hạ cam mềm phải kể đến như:
-
Nổi các vết sưng viêm nhỏ màu đỏ hồng xung quanh cơ quan sinh dục. Sau khoảng thời gian ngắn, chúng sẽ vỡ ra và hình thành các vùng lở loét, nhiễm trùng.
-
Gây đau rát, khô nóng, ngứa ngáy và mùi hôi tanh ở vùng kín của người bệnh.
-
Cảm giác bí bách khi đi vệ sinh và bị đau đớn mỗi khi đại tiện, tiểu tiện.
-
Các vết tổn thương, loét thường có kích thước trung bình khoảng 0,5-2cm và dễ bị vỡ ra, chảy máu và tiết mủ trắng khi bị chạm vào hoặc quan hệ tình dục.
-
Nhiều vùng lở loét nham nhở trên cơ thể ở đùi với màu xám, vàng xám.
-
Bị đau khi giao hợp; bên bẹn đùi có vết lở loét hoặc sưng hạch.
-
Sưng lớn hoặc áp xe ở ngay vị trí của hạch bạch huyết.
-
Mọc nhiều tụ mủ, lúc vỡ mủ chảy ra đặc sánh, keo sệt như kem.

Nguyên nhân mắc bệnh hạ cam mềm ở nam giới
Bệnh hạ cam mềm ở nam giới là do nhiễm khuẩn H. Ducreyi xâm nhập vào thượng bì sau khi có tiếp xúc. Chúng có thể tấn công cơ thể và lây lan mầm bệnh qua mô da, niêm mạc qua các con đường sau đây:
Tình dục không an toàn
Bộ phận sinh dục của người bệnh hạ cam mềm thường là nơi tập trung các vết lở loét, chảy dịch, máu mủ có chứa mầm bệnh. Vậy nên khi quan hệ không dùng biện pháp bảo vệ, không đeo bao cao su thì hạ bộ nam giới sẽ bị dính những chất dịch nhầy chứa khuẩn Haemophilus ducreyi. Nó sẽ nhanh chóng tiếp cận và tấn công lên lớp niêm mạc để gây bệnh một cách nhanh chóng. Đặc biệt là khi quan hệ mạnh bạo khiến dương vật, âm đạo chảy máu hoặc quan hệ qua hậu môn thì nguy cơ lây nhiễm càng tăng cao gấp nhiều lần.
Các con đường lây nhiễm khác
Ngoài nguyên nhân lây nhiễm chủ yếu là qua tình dục thiếu an toàn thì hạ cam mềm ở nam giới còn có thể bị truyền qua:
-
Người lành tiếp xúc, dính chất dịch tiết chứa mầm bệnh qua đồ dùng cá nhân, đồ ăn thức uống,...
-
Lan rộng phạm vi nhiễm săng hạ cam mềm ra các vùng khác trên cơ thể do gãi vùng mụn mủ chảy máu, dịch sau đó gãi sang nơi da lành.

Tác hại, biến chứng của bệnh hạ cam mềm
Căn bệnh phụ khoa hạ cam mềm nguy hiểm gây ra rất nhiều tác hại nghiêm trọng ảnh hưởng đến đời sống và sức khỏe người bệnh. Đặc biệt là hạ cam mềm ở nam giới thường có những biểu hiện nặng và rõ ràng hơn người nữ. Một số những biến chứng nguy hiểm của căn bệnh phụ khoa này đó là:
-
Làm nổi hạch ở bẹn và xuất hiện nhiều ổ tụ mủ, áp xe gây viêm loét nặng và thủng lỗ dò gây mất thẩm mỹ cũng như tạo nên các vết tổn thương sâu.
-
Gây sưng tấy hạch bạch huyết tạo đà cho bệnh lý phù nề tại đường sinh dục, đặc biệt là ở dương vật nam giới. Nó còn kéo theo cả tình trạng tắc nghẽn bao quy đầu hay lan sưng viêm xuống đùi và bắp chân.
-
Tăng tỷ lệ lây nhiễm nhiều căn bệnh tình dục khác hoặc khiến đường sinh sản bị nhiễm khuẩn khiến khó đậu thai.
-
Vết loét, mủ tụ trên bộ phận sinh dục của người bệnh sẽ tạo điều kiện và môi trường thuận lợi cho virus HIV phát triển.
Nguy cơ mắc bệnh hạ cam mềm
Những ai có khả năng mắc bệnh hạ cam mềm cao
Bệnh hạ cam mềm có khả năng lây nhiễm cực cao nên bất cứ ai cũng có khả năng mắc phải. Tuy nhiên hạ cam mềm ở nam giới lại xuất hiện nhiều và dễ mắc cao hơn nữ, với tỷ lệ khoảng 3:1.

Yếu tố làm tăng nguy cơ mắc bệnh hạ cam mềm
Đặc biệt những đối tượng sau là những người dễ nhiễm phải căn bệnh phụ khoa này nhất:
-
Người sử dụng, buôn bán các dịch vụ mại dâm.
-
Người quan hệ với nhiều bạn tình, không có lối sống tình dục chung thủy.
-
Người quan hệ mạnh bạo, không lành mạnh, không dùng biện pháp bảo vệ.
-
Người nghiện bia rượu, thường xuyên sử dụng chất kích thích.
Phương pháp chẩn đoán và điều trị bệnh hạ cam mềm
Xét nghiệm và chẩn đoán bệnh hạ cam mềm
Khi đến khám phụ khoa bệnh hạ cam mềm, đầu tiên bác sĩ sẽ tiến hành chẩn đoán xác định để phát hiện những triệu chứng lâm sàng của bệnh. Sau đó để chẩn đoán được chính xác hơn thì bạn có thể sẽ phải kiểm tra qua các xét nghiệm sau:
-
Nhuộm soi: Lấy dịch tiết ở đáy vết loét đem nhuộm gram để soi và tìm kiếm khuẩn H. Ducreyi.
-
Nuôi cấy và phân lập: Nuôi cấy mẫu bệnh phẩm trên môi trường hemoglobin và huyết thanh giàu dưỡng chất để phân lập và đợi vi khuẩn phát triển.
-
Xét nghiệm PCR (M-PCR): Với độ nhạy và tính đặc hiệu cao, bệnh sẽ được xác định nhanh, chính xác.

Điều trị hạ cam mềm hiệu quả
Vì bệnh hạ cam mềm tiến triển rất nhanh nên khi có dấu hiệu lâm sàng chắc chắn theo chẩn đoán của bác sĩ, người bệnh nên tiến hành điều trị bệnh ngay. Dưới đây là những phương pháp chữa bệnh hạ cam mềm mang lại hiệu quả tốt và phổ biến:
Chữa trị bệnh bằng thuốc kháng sinh
Đây là một cách thịnh hành để giảm đi triệu chứng và diệt trừ vi khuẩn quanh các vết lở loét. Tùy theo tình trạng cũng như mức độ nặng nhẹ mà bác sĩ sẽ vạch ra phác đồ điều trị hạ cam mềm phù hợp nhất. Trong đó, các loại kháng sinh hay dùng để trị căn bệnh này phải kể đến như azithromycin, ceftriaxone, spectinomycin,...
Chữa trị bệnh bằng phẫu thuật
Nếu bệnh đã phát triển với những vết loét mủ, áp xe lớn thì phẫu thuật bằng kim thông sẽ mang lại kết quả nhanh chóng và cao hơn thuốc.
Cách phòng ngừa bệnh hạ cam mềm
-
Tình dục an toàn và biết cách bảo vệ bản thân bằng cách đeo bao cao su.
-
Tránh giao hợp mạnh bạo gây rách và tăng nguy cơ nhiễm.
-
Không quan hệ với nhiều người nhất là những ai bị nghi nhiễm.
-
Tới khám phụ khoa và điều trị ngay khi nghi ngờ lây nhiễm từ bạn tình.

Phòng khám phụ khoa Minh Khai nơi chuyên điều trị bệnh hạ cam mềm
Ngay sau khi nhận thấy dấu hiệu mắc bệnh hạ cam mềm, người nghi nhiễm nên đến khám phụ khoa để được điều trị kịp thời. Và phòng khám phụ khoa Minh Khai sẽ là cơ sở khám chữa uy tín, chất lượng có thể điều trị hiệu quả căn bệnh này. Với khả năng chẩn đoán chính xác, bạn sẽ sớm được vạch ra phác đồ điều trị đúng đắn giúp đẩy lùi, giảm nhẹ triệu chứng, biến chứng của bệnh hạ cam mềm rất nhanh chóng cũng như không để lại sẹo.